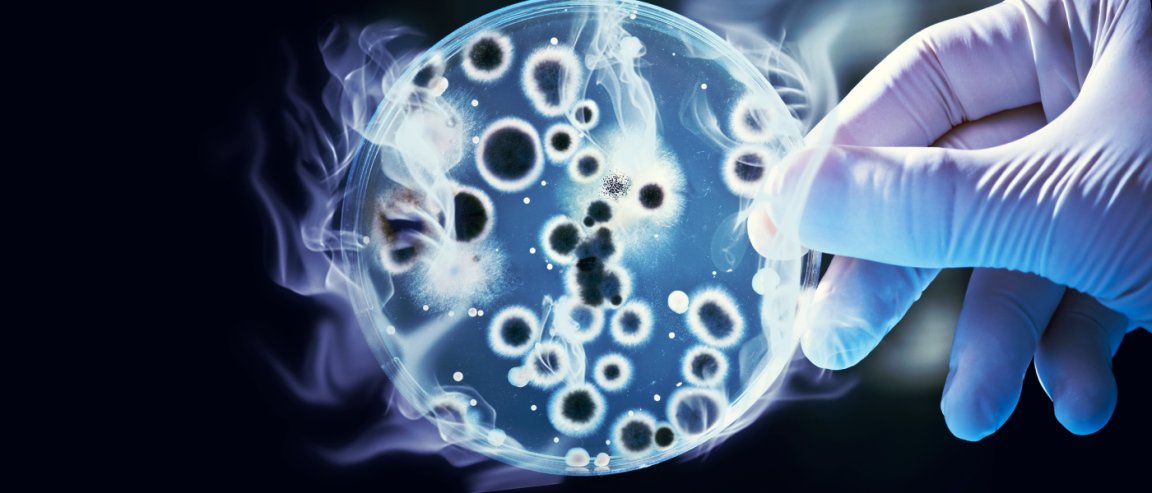

Nitrogenase 101
The quest for making fuel ‘out of thin air’ is on at the University of Washington.
In a recent study published in the Proceedings of the National Academy of Sciences, researchers have engineered a bacterium that could boost the process of turning carbon dioxide into methane gas into just a single enzymatic step, by using an enzyme called “nitrogenase” as a catalyst.
The enzyme is not a completely lab created catalyst, as it does occur in nature. In it’s natural state, nitrogenase does help bacteria, according to Scientific American, “turn inert atmospheric nitrogen gas into reactive ammonia in a process called nitrogen reduction, or nitrogen fixation.”
Co-author of the publication, Caroline Harwood, a professor of microbiology at the University of Washington, was intrigued by the enzyme’s ability of performing this “phenomenally difficult reaction.” She and the team began to test if they could change the way the enzyme behaves to have it react with other substrates to produce other useful forms.

How it Works
As Scientific American explains the process, the bacterium, R. palustris, was also modified to increase the production levels of the engineered nitrogenase. Just as in the natural reaction, the enzyme needed to be fueled by sunlight to produce the energy necessary to complete the reaction. The results were promising. Still, the process from carbon dioxide to methane was nowhere near as efficient as the natural process of nitrogen to ammonia. “The normal enzyme makes about two hydrogens for every [molecule of] ammonia,” Harwood said. “The altered enzyme makes a thousand hydrogens for every molecule of methane.”
Even taking this into consideration, many scientists are energetically looking forward to more study. This discovery just a starting point to using nitrogenase’s abilities to understand how a biological system can marshal resources to produce an energy-rich hydrocarbon in just one enzymatic step.